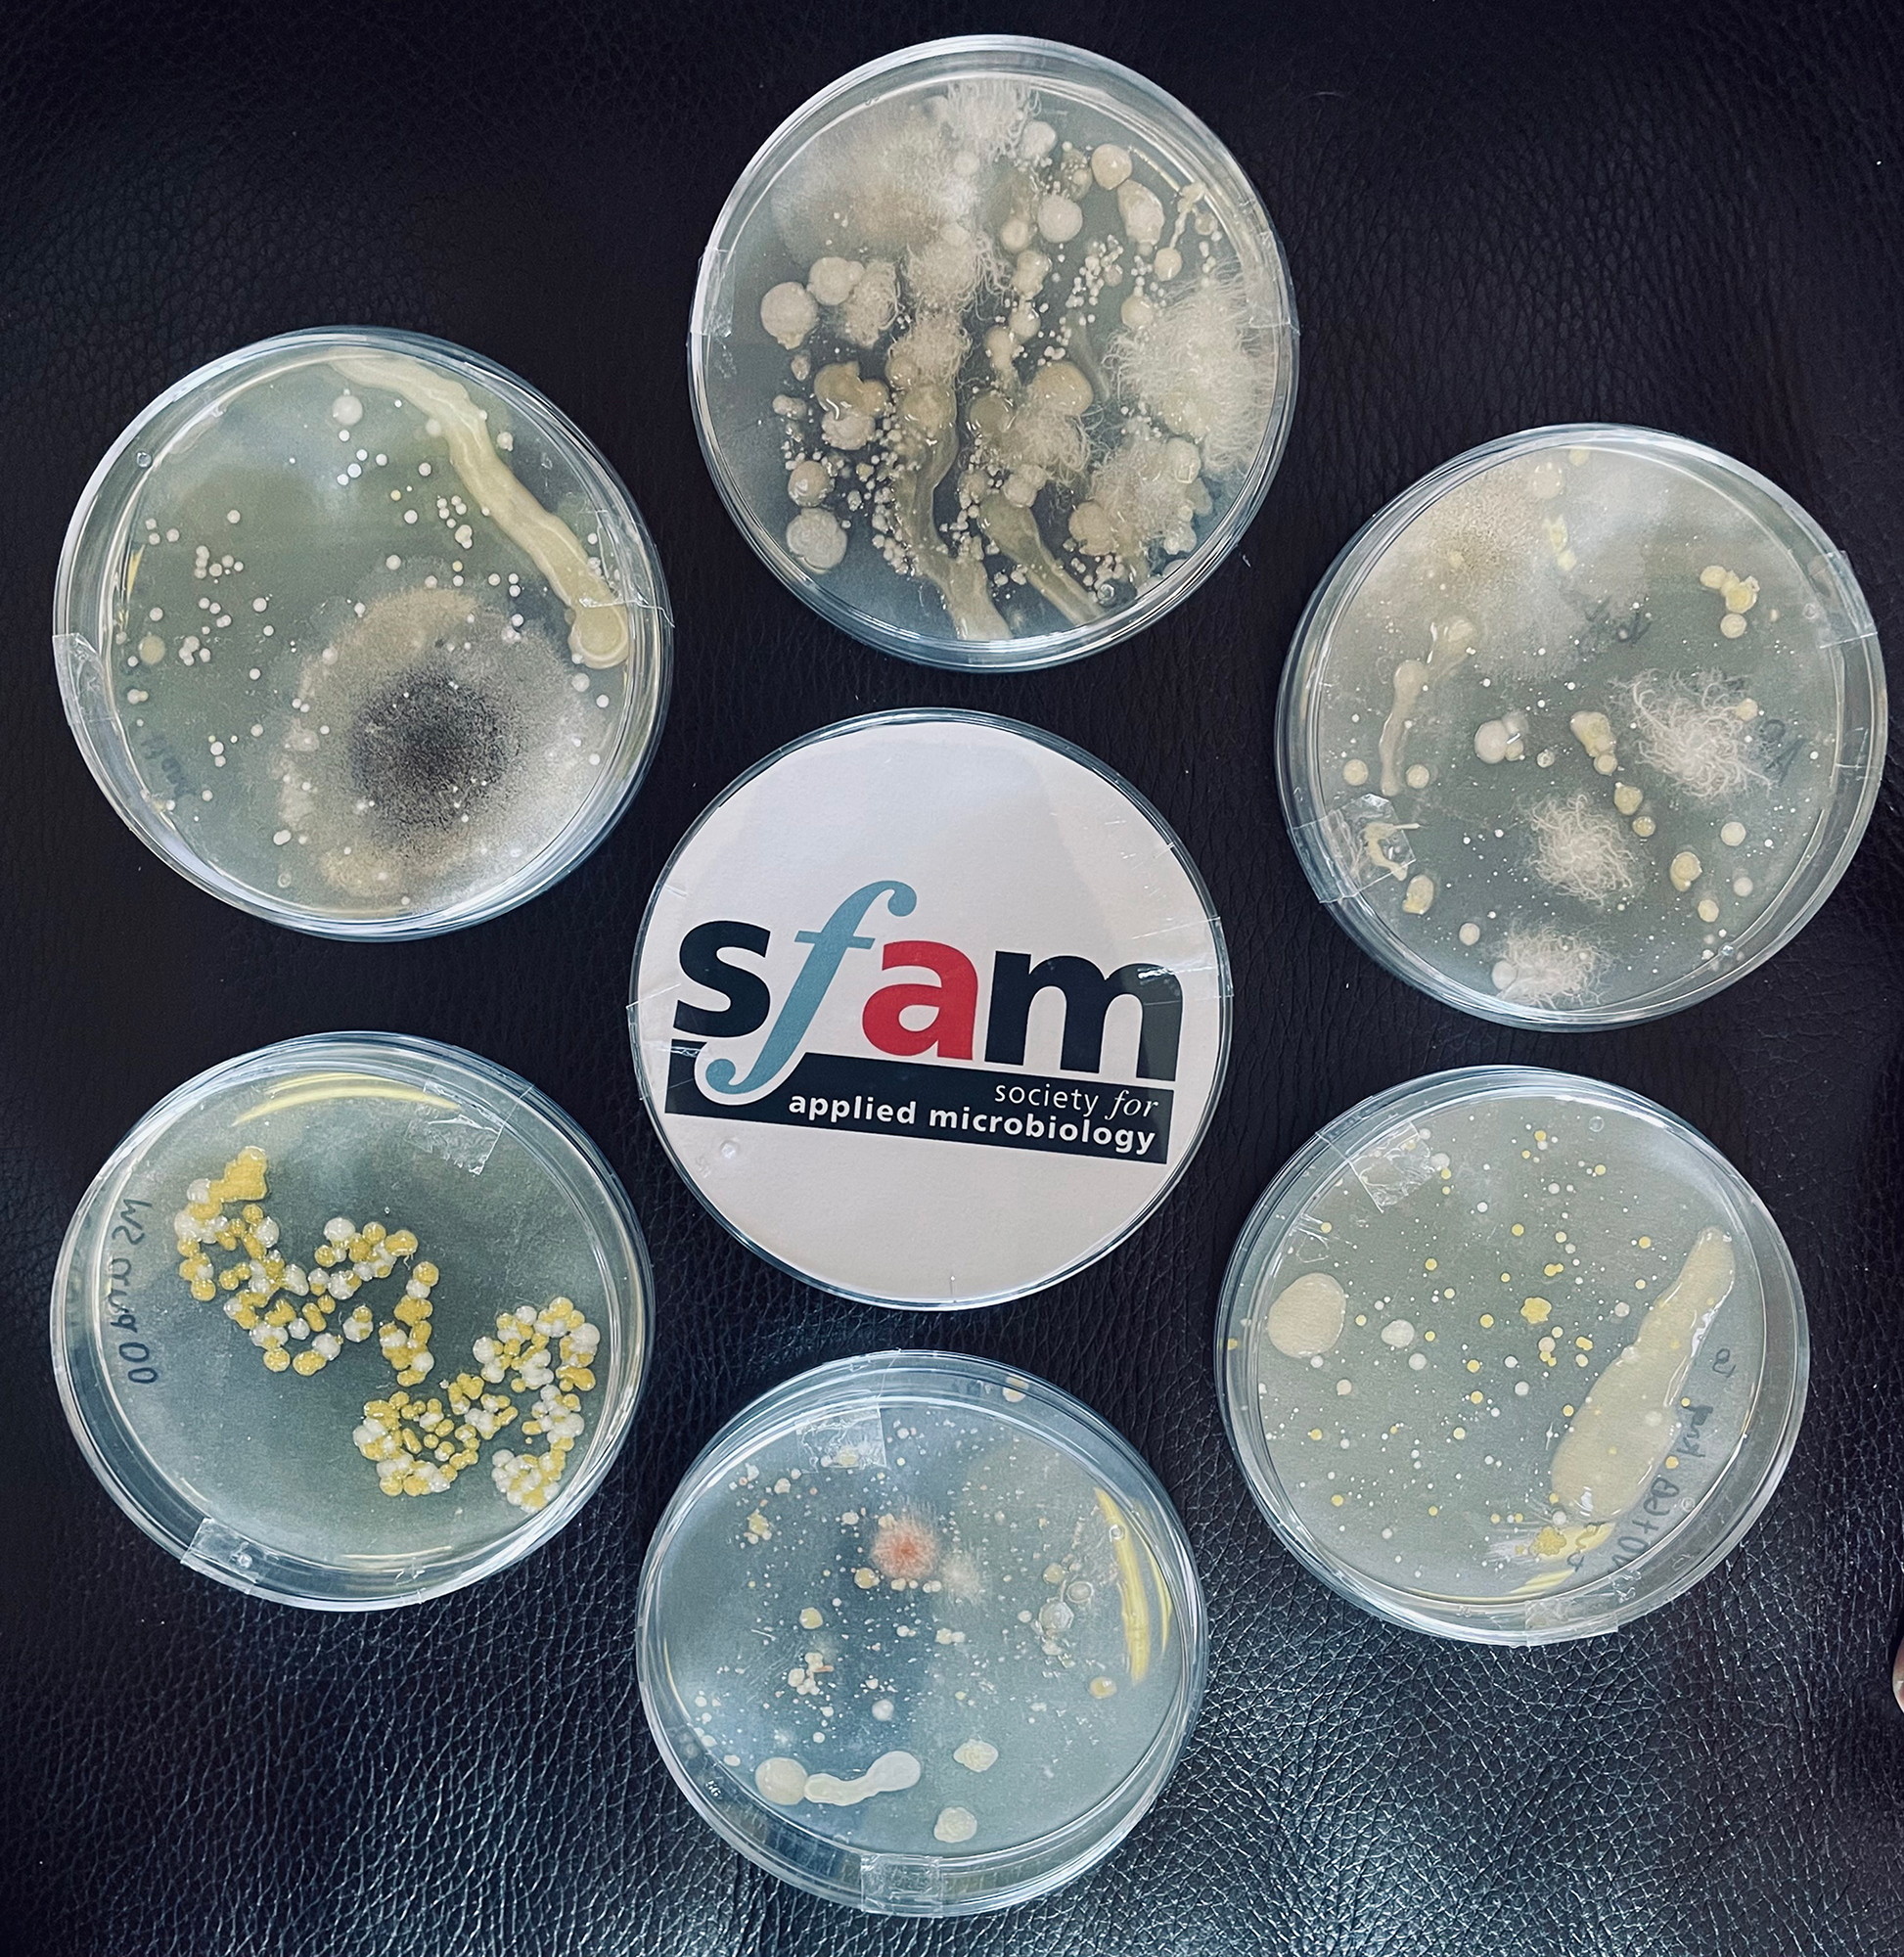
Samantha Maclean Outreach 1.jpg
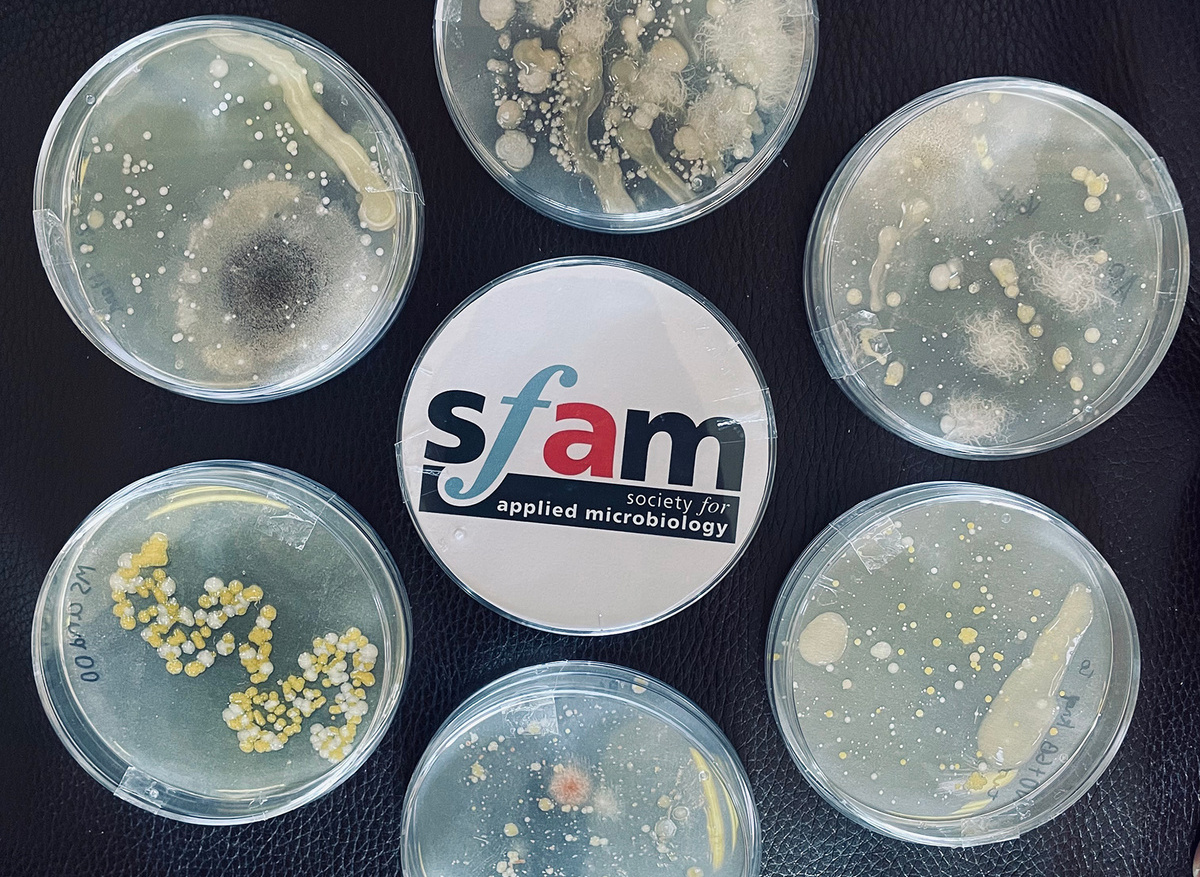
Mock agar plates
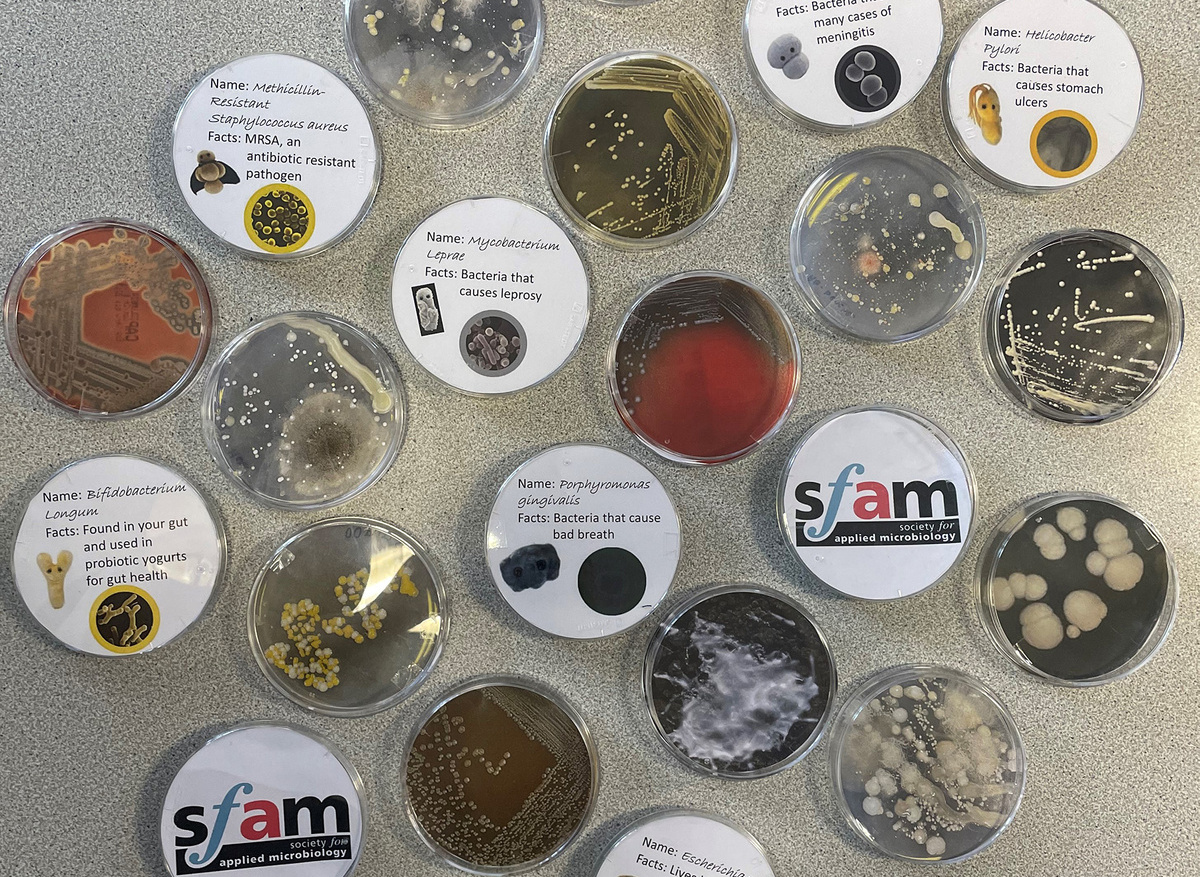
Mock agar plates

Dr McLean's primary school outreach
These activities are part of an ongoing annual outreach connection between Dr Samantha McLean and a local primary school to improve the students microbiology literacy. This year thirty Y5 and thirty four Y6 pupils at Whiston Junior and Infant School took part in the activities along with three teachers and two teaching assistants. The primary aim of this ongoing outreach work is to improve microbiology education in local primary schools, which is perhaps more important than ever due to the current pandemic.
Dr McLean visited the school for two days during the week and provided the children with a general introduction to microbiology. Through practical activities students gained hands-on experience of how microorganisms spread throughout the environment and the variety of microorganisms that live all around us (e.g. see images of mock agar plates in the slideshow below). This information was related to everyday activities that children undertake such as washing hands, which ensured that students could relate to the concepts taught. Interactive Kahoot quizzes were a huge student favourite and further developed their understanding of the roles that microorganisms play in our lives in a fun and engaging way.
The students were able to carry out their own experiment swabbing their environment to find the different types of microbes that live there. They learned how to generate and test a hypothesis based on what they thought they would find and then how to change their hypothesis if the evidence suggested they should. The students loved making hair gel biofilms to understand more about the properties of these microbial communities and how this related to brushing teeth. But of course, during a pandemic it was important to address the topic of COVID-19. Therefore, some of the learning and activities were modified to help the students better understand what SARS-CoV-2 is, how it spreads and why the “hands, face, space” rules are important. They were taught how microbes, such as SARS-CoV-2 can spread via the glitter microbe experiment and saw first-hand the importance of good hand washing using the GloGerm lotion. The students were also amazed by the Curioscope Virtual-tee that showed them the inside of the human body, where they were able to see organs and learn about circulation, respiration and the digestive tract and how microbes interact with those pathways.
The students were highly engaged and enthusiastic throughout the whole experience, asking many excellent questions and loving the hands-on approach to microbiology learning. It is clear to see from the student letters that I received after the activities that the students really appreciated the opportunity to learn microbiology, that they learned a lot and that they had a great deal of fun doing so (two example letters are attached below).
This kind of activity would be very difficult to continue without the support of societies such as SfAM, the funding provided has not only allowed these outreach opportunities to continue but has also enhanced the provision that we can provide. So on behalf of myself and the school, I would like to once again thank you for your support.
Dr Samantha McLean